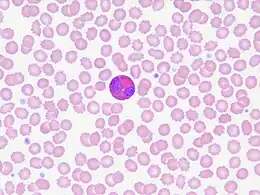
Description de l'image Eosinophils in peripheral blood.jpg.

Éosinophilie
| Spécialité | Hématologie |
|---|
| DiseasesDB | 4328 |
|---|---|
| eMedicine | 199879 |
| MeSH | D004802 |
| Patient UK | Eosinophilia |
![]() Mise en garde médicale
Mise en garde médicale
L'éosinophilie (ou hyperéosinophilie) sanguine se définit comme l'augmentation permanente de la valeur de la numération des polynucléaires éosinophiles au-delà d'un seuil généralement admis de 500 cellules par millimètre cube de sang (0,5 × 109 l−1).
Causes
Schématiquement, on peut diviser les éosinophilies en deux groupes :
- les éosinophilies « réactionnelles » liées à une réponse immunitaire de type Th2 (allergique) dirigée contre des allergènes courants (pneumallergènes, trophallergènes, substances chimiques et / ou médicamenteuses) ou des antigènes parasitaires ;
- les éosinophilies « non allergiques », liées à des affections comportant un aspect dysimmunitaire (lymphomes ou leucémies, maladies de Crohn et de Whipple, collagénoses, angéites nécrosantes) ou d'étiologie inconnue (syndrome hyperéosinophilique [SHE]). Ce dernier cas représente 1 % des cas[1].
En parasitologie, ce sont surtout les helminthiases qui sont susceptibles d'entraîner une éosinophilie notable, bien que cette anomalie puisse manquer. Exceptionnellement, des protozooses comme la toxoplasmose ou l'isosporose peuvent être en cause. La gale peut également être responsable d'une éosinophilie.
Diagnostic
L'interrogatoire constitue le premier pas — indispensable — de l'exploration d'une éosinophilie.
Toute prise médicamenteuse récente, même anodine, doit faire suspecter une éosinophilie liée au traitement. Certaines substances (bêta-lactamines, héparine calcique, hypocholestérolémiants) ont un pouvoir éosinophilogène notoire, mais toute drogue peut a priori être suspectée.
Avant d'aller plus loin dans les investigations biologiques, on doit alors refaire un hémogramme à distance (2 à 3 semaines) de l'arrêt ou du changement du traitement, ce type d'éosinophilie cédant rapidement avec la disparition du stimulus allergisant. Le patient doit donner sa profession et être interrogé sur son mode de vie en métropole, sur la région où le service militaire a été effectué (pour les personnes encore concernées), sur ses voyages ou séjours hors Union européenne, et pour les migrants, sur le pays d'origine. Cette partie de l'interrogatoire doit être particulièrement minutieuse, beaucoup de personnes occultant quasi-systématiquement voyages ou séjours brefs et / ou datant de plus de quelques années. Toute notion de séjour ou de voyage exotique devra donc faire ajouter aux investigations biologiques la recherche des helminthiases tropicales les plus courantes avec un examen parasitologique des selles.
Le patient devra également amener à la consultation tous les résultats d'hémogramme en sa possession afin d'évaluer l'ancienneté et le type (stable ou fluctuante) de son éosinophilie.
La découverte d'une éosinophilie doit faire exécuter, dans un délai de 2 à 3 semaines, un hémogramme de contrôle. Nombre d'éosinophilies, par exemple chez les sujets atopiques en saison pollinique, sont dues à des allergisations transitoires. Spontanément et rapidement résolutives, elles ne doivent pas en principe faire l'objet d'investigations approfondies. À l'inverse, l'hémogramme de contrôle peut montrer une éosinophilie rapidement croissante, pouvant évoquer une helminthiase en phase d'invasion. On dose ensuite les marqueurs de l'inflammation (VS et CRP). En cas d'infection helminthique, une inflammation objectivée par des perturbabtions de la VS et du dosage de la CRP ne se voit en principe qu'au cours de la phase d'invasion, dite « toxi-infectieuse », de certaines parasitoses (bilharzioses, distomatose à F. hepatica, trichinellose, formes majeures de la toxocarose (larva migrans viscérale). La clinique souvent très évocatrice, les renseignements épidémiologiques et l'éosinophilie rapidement croissante doivent alors faire éliminer ces affections en priorité.
Les examens de deuxième intention commencent par le dosage des Immunoglobulines E (IgE) totales. Il s'agit d'un examen « pivot ». L'augmentation du titre des IgE totales due aux helminthiases procède d'un mécanisme encore imparfaitement connu. Elle a été décrite pour la première fois en 1968 chez des enfants éthiopiens souffrant principalement d'ascaridiose et a été retrouvée ensuite dans la plupart des helminthiases. Cette augmentation est en principe importante, au-delà de 500 kUI/L. Elle peut manquer chez les individus non répondeurs ou porteurs d’une helminthiase ancienne. Les éosinophilies induites par des substances chimiques (médicaments), ou non réactionnelles (non allergiques), ne s'accompagnent généralement pas d'une élévation du taux des IgE totales. On effectue ensuite le dosage des IgE spécifiques. La recherche et le dosage des IgE spécifiques des principaux pneumallergènes (acariens, pollens d'arbres, d'herbacées et de graminées, épithéliums de chat et moisissures) dépiste la plupart des sujets atopiques. L'examen parasitologique des selles est capital, la coprologie parasitaire étant la première des investigations pouvant conduire à un diagnostic de certitude. Il faut savoir que des selles émises la veille du passage au laboratoire peuvent à la rigueur convenir si elles ont été conservées dans un endroit frais (mais pas au réfrigérateur, une nuit à + 4 °C tuant, par exemple, les larves d'anguillule). Devant une notion d'éosinophilie tropicale, on ajoute à la coprologie parasitaire, en fonction des renseignements épidémiologiques une recherche de microfilaires, et un examen parasitologique des urines à la recherche d'œufs de bilharzies.
Les sérodiagnostics des helminthiases sont complémentaires et non exclusifs des examens microscopiques décrits ci-dessus. En principe, ils sont effectués de façon groupée. Un « panel » courant comprend les sérologies de la distomatose, de l'hydatidose, de la strongyloïdose, et de la toxocarose. En cas de notion d'éosinophilie tropicale, les diagnostics des filarioses et des schistosomoses sont ajoutés.
L’exploration des éosinophilies, même limitées aux formes réactionnelles, est donc une démarche complexe mais nécessaire, qui requiert une étroite collaboration entre le clinicien et le biologiste. Correctement effectuée, elle donne des résultats satisfaisants et permet notamment le diagnostic d'helminthiases chroniques passées inaperçues.
Le niveau d'éosinophilie peut apporter des indices quant à sa cause : si elle est d'origine allergique, elle dépasse rarement 2000 éléments par millimètre cube[1] et des chiffres plus importants doivent faire chercher d'autres causes. De même la présence d'éosinophiles anormaux et l'atteinte d'autres lignées sanguines sont plus en faveur d'une origine médullaire.
Complications
- Lésions des tissus musculaires et surtout les tuniques cardiaques.
- Infiltrations tissulaires.
Traitements
- Traitement de la cause
- Corticothérapie dans les formes sévères et non infectieuses
Notes et références
- 1 2 Sims H, Erber WN, Investigation of an incidental finding of eosinophilia, BMJ, 2011;342:d2670
- Portail de la médecine
- Portail de l’hématologie